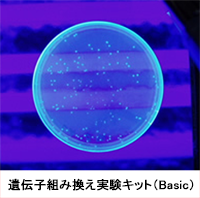
DNA抽出キット
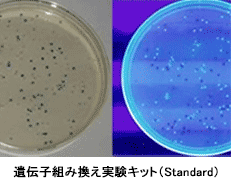
遺伝子組み換えキットStadard

- 日本微生物クリニック株式会社TOP
- 取扱商品
- バイオテクノロジー教材キット
バイオテクノロジー教材キットBio Education Kits
株式会社島津理化とのコラボレーションにより,弊社で開発した教材キットをご提供しております.小学校高学年から大学生まで幅広く使って頂けるDNA抽出実験キット,遺伝子組換え実験キット(Basic Version, Standard Version)電気泳動実験キットの4種類の実験キットで,バイオテクノロジーの基礎を修得することが可能です.
DNA抽出実験キットDNA Extraction Kit
動物細胞(鶏のレバー)からDNAの抽出をおこなうための薬品類,マニュアルの一式をキットにまとめました。DNAを可視化することで分子生物学への興味を深めることが出来ます。
キットの特徴
- 特別な試薬を使用しません。
- 特別な機材を必要としません。
- 50分の授業時間内に実験が終了します。
- 難しい試薬の調整はありません。
・タンパク質分解酵素を使用しないため、試薬類は常温で長期間保管可能です。
・鳥レバー以外でも、肉であればほとんどの試料からDNAを抽出することができます。
(得られるDNAの量が少ない場合も目に見える量を抽出することができます)
・低価格なので、班単位ではなく生徒全員に実験を体験させることができます。
・フェノールやクロロホルム等の危険な試薬を一切使用していません。
・実験操作は約30分で終了するため、授業時間の前後10分間を、説明や解説に
あてることができます。

実験の目的
多くの細胞には1つの核が存在し、その内部には染色体があります。染色体は、遺伝情報の本体であるDNA(デオキシリボ核酸)によって構成されています。 DNAは、アデニン(A)、チミン(T)、シトシン(C)、グアニン(G)の4種類の塩基が連なり、2重らせん構造をとっています。DNAの情報に従ってタンパク質が合成されることから、DNAはいわば設計図の役割を果たしています。これは微生物から植物、動物、ヒトに至る全ての生物に共通であることです。
分子生物学において、遺伝子を扱った実験は様々な場面で行われています。このような実験には組織や細胞から対象とするDNAを取り出す必要があります。
本キットでは、分子生物学を学ぶにあたって、必要不可欠なDNAの抽出を体験することができます。教科書だけで終わっていた授業に替わり、生徒が実際に体験することによって興味を抱き、より探求心を深めることができます。
遺伝子組み換え実験キット(Basic)GM Kit / Basic
遺伝子組換え操作を安全かつ簡単に学ぶことができます。(対象:中学校3年~高等学校2年)
キットの特徴
- 特別な試薬を使用しません。
- 特別な機材を必要としません。 ※恒温槽、インキュベーター、UVランプ等が必要
- 事前の難しい準備は必要ありません。
- オートクレーブバック付属で廃棄が簡単です。
- 遺伝子組換え操作を安全かつ簡単に学ぶことができます。
・病原性のない安全な大腸菌( E.coli K-12株)を使用しています。
・先生の事前の準備を少なくする為、あらかじめ培養プレート等は作製してあります。
・先生が実験指導に専念できるように、各試薬等はあらかじめ班ごとに分けています。
・使用したプレート等の廃棄はオートクレーブバックにまとめ、滅菌後一般ゴミとして
廃棄できます。(一部自治体によって違いますのでご確認下さい。)
実験の目的
多くの細胞には1つの核が存在し、その内部には染色体があります。染色体は、遺伝情報の本体であるDNA(デオキシリボ核酸)によって構成されています。 DNAは、アデニン(A)、チミン(T)、シトシン(C)、グアニン(G)の4種類の塩基が連なり、2重らせん構造をとっています。DNAの情報に従ってタンパク質が合成されることから、DNAはいわば設計図の役割を果たしています。これは微生物から植物、動物、ヒトに至る全ての生物に共通であることです。
分子生物学において、遺伝子を扱った実験は様々な場面で行われています。このような実験には組織や細胞から対象とするDNAを取り出す必要があります。
本キットでは、分子生物学を学ぶにあたって、必要不可欠なDNAの抽出を体験することができます。教科書だけで終わっていた授業に替わり、生徒が実際に体験することによって興味を抱き、より探求心を深めることができます。
遺伝子組み換え実験キット(Standard)GM Kit / Standard
遺伝子組換え操作を安全かつ簡単に学ぶことができます。(対象:高等学校・専門学校・大学基礎)
キットの特徴
- 特別な試薬を使用しません。
- 特別な機材を必要としません。 ※恒温槽、インキュベーター、UVランプ等が必要
- 事前の難しい準備は必要ありません。
- オートクレーブバック付属で廃棄が簡単です。
- 遺伝子組換え操作を安全かつ簡単に学ぶことができます。
- 遺伝子発現調節機構を学ぶことができます。
- 実験結果を視覚的にとらえることができます。
・病原性のない安全な大腸菌( E.coli K-12株)を使用しています。
・IPTGとX-galを使用したLacZ遺伝子の発現調節が学べます
・先生の事前の準備を少なくする為、あらかじめ培養プレート等は作製してあります。
・先生が実験指導に専念できるように、各試薬等はあらかじめ班ごとに分けています。
・使用したプレート等の廃棄はオートクレーブバックにまとめ、滅菌後一般ゴミとして
廃棄できます。(一部自治体によって違いますのでご確認下さい。)
遺伝子導入について
大腸菌には、もともとのゲノムDNAとは別にプラスミドと呼ばれる環状のDNAがあります。このプラスミドには通常ある機能を持つ遺伝子が含まれており、このプラスミドを共有することにより大腸菌は様々な環境に対応する形質を獲得しています。
本キットではこの特性を利用し、あらかじめ蛍光蛋白質(GFP)とガラクトシダーゼ(LacZ)の遺伝子を組み込んだ 2種類のプラスミド(pBR322)を同時に大腸菌に導入することにより、それぞれ形質転換させます。また、選択マーカーとしてそれぞれ同じプラスミド上に薬剤耐性遺伝子(アンピシリン耐性遺伝子)も導入されています。

電気泳動実験キットElectrophoresis Experiment Kit
本キットは分子生物学の実験において頻繁に用いられ、重要な操作として位置付けられているDNAの切断、アガロースゲル電気泳動法を体験することができます。
キットの特徴
- 分子生物学の基礎技術となる、制限酵素によるDNAの切断、電気泳動法について
学ぶことができます。 - 事前の難しい準備は必要ありません。
- 基本的に実験操作は、溶液を混ぜる、交換するのみの非常に簡単な作業です。
- DNAの検出には、強力な発癌性のある エチジウムブロマイド(EtBr)を使用せず、
安全性の高い染色剤*(Mupid-Blue)を使用します。 - 先生の事前の準備を少なくするため、あらかじめアガロースゲルは作製してあります。
- 本キットは1セットを1班分(4名)とし、5セット入りの20名用です。
・1セットにはDNA サンプルが4本付属しているので、1人1サンプルを担当して実験を
行うことにより、1セットを4名で使用することができます。
これによって1キットを20名で使用することができます。

- 日本微生物クリニック株式会社TOP
- 取扱商品
- バイオテクノロジー教材キット